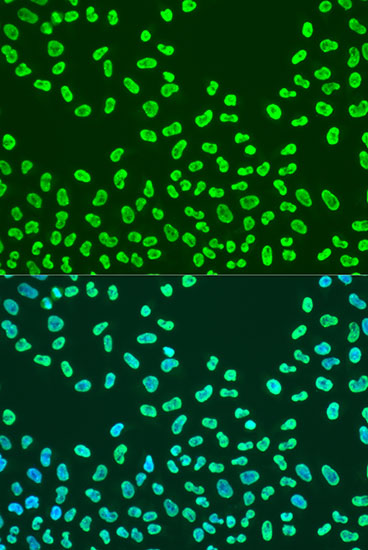
Immunofluorescence - KHDRBS2 Polyclonal Antibody

-
Product Name
KHDRBS2 Polyclonal Antibody
- Documents
-
Description
Polyclonal antibody to KHDRBS2
-
Tested applications
IF
-
Species reactivity
Human
-
Alternative names
KHDRBS2 antibody; SLM-1 antibody; SLM1 antibody; KH RNA binding domain containing, signal transduction associated 2 antibody
-
Isotype
Rabbit IgG
-
Preparation
Antigen: A synthetic peptide corresponding to a sequence within amino acids 200 to the C-terminus of human KHDRBS2 (NP_689901.2).
-
Clonality
Polyclonal
-
Formulation
PBS with 0.02% sodium azide, 50% glycerol, pH7.3.
-
Storage instructions
Store at -20℃. Avoid freeze / thaw cycles.
-
Applications
IF 1:50 - 1:200
-
Validations
Immunofluorescence - KHDRBS2 Polyclonal Antibody
Immunofluorescence analysis of U2OS cells using KHDRBS2 antibody at dilution of 1:100. Blue: DAPI for nuclear staining.
-
Background
RNA-binding protein that plays a role in the regulation of alternative splicing and influences mRNA splice site selection and exon inclusion. Binds both poly(A) and poly(U) homopolymers. Phosphorylation by PTK6 inhibits its RNA-binding ability (By similarity). Induces an increased concentration-dependent incorporation of exon in CD44 pre-mRNA by direct binding to purine-rich exonic enhancer. Can regulate alternative splicing of NRXN1 in the laminin G-like domain 6 containing the evolutionary conserved neurexin alternative spliced segment 4 (AS4) involved in neurexin selective targeting to postsynaptic partners. Regulates cell-type specific alternative splicing of NRXN1 at AS4 and acts synergystically with SAM68 in exon skipping. In contrast acts antagonistically with SAM68 in NRXN3 exon skipping at AS4. Its phosphorylation by FYN inhibits its ability to regulate splice site selection. May function as an adapter protein for Src kinases during mitosis.
Related Products / Services
Please note: All products are "FOR RESEARCH USE ONLY AND ARE NOT INTENDED FOR DIAGNOSTIC OR THERAPEUTIC USE"
